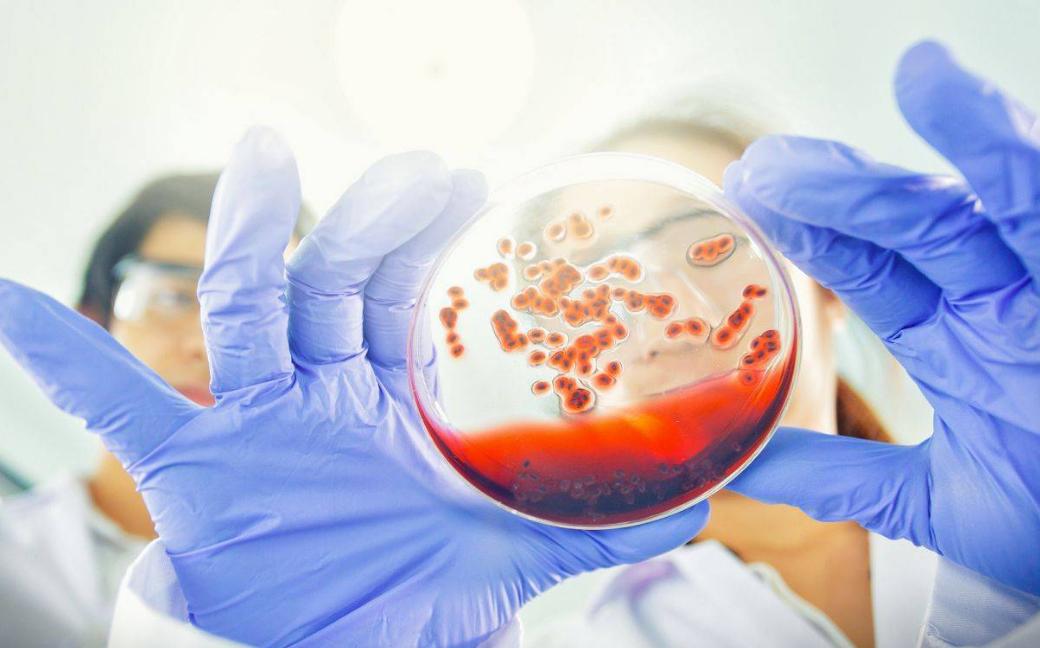
为什么女人不愿意去医院检查,为啥妇科检查有人做不了

想必很多人还记得新年伊始的一个热搜“江苏一男医生网上发布患者妇科手术照”,原来是,江苏省昆山市第一人民医院友谊院区妇产科医生姜某,在社交平台发布女性患者私密部位照片,甚至配文“上班绝对严肃,下班放浪形骸”,这种严重丧失医生职业道德的行为一度被全社会所唾弃。

根据当时的新闻报道,姜某发出的图片中对患者的私密部位并没有进行马赛克处理,而且网友戏问其所在科室的时候,他还毫不避讳的标明是妇科。
很多人对这种严重缺乏医德和职业道德规范的恶劣行为表示愤怒。也有不少女性表示本来去医院检查妇科的时候就感觉很“羞耻”,看到这种新闻更是不敢去检查了。
其实女性羞于妇科检查并不在少数,据《中国育龄女性生殖健康研究报告2022》显示:
我国育龄期女性自我感觉健康较差的比例高达33.5%,还有约51.3%的女性在感觉不舒服的时候并不去医院,而是自行用药。
分析其原因可能与女性健康认知不足、主动维护健康意识薄弱、羞于去医院检查或治疗等都有很大关系。

尽管很多妇科专家一再呼吁女性群体进行健康检查的时候对于“隐私部位”要做到“应检尽检”,但是去医院检查,尤其是进行妇科检查时碰到男医生的“羞耻感”,严重限制了她们维护自己健康的脚步。
同时还有很多人也认为自己没什么不舒服,不检查也没什么事儿。但是想要保持健康,定期前往医院进行妇科检查是至关重要的。
为什么女性要定期进行妇科检查?
有专家提到,定期进行妇科检查对于女性来说是一份无形的健康保险。因为相比于男性来说,女性身体的生理构造更为特殊,即便已经存在妇科疾病,但是在早期并没有很明显的症状出现。一旦自己感觉出不适,极大可能已经错过了最佳的治疗时机。

女性的内分泌系统和生殖系统一旦发生异常,会出现如白带增多、豆腐渣样白带以及异味等,甚至还会有不规则阴道出血、腹部疼痛、乳房疼痛等症状,严重者会患上乳腺癌、宫颈癌等重大疾病。
定期妇科检查的重大目的也是为了预防这些妇科癌症。
女性在成年后尤其是有*生活性**后的女性,身体各方面已经发育成熟,加上工作生活压力大、不良生活习惯、睡眠不足、运动缺乏、滥用补品化妆品等因素,导致更多女性成为癌症高发人群。因此定期的妇科检查可以帮助及早发现妇科疾病,有效预防和治疗,将妇科疾病消灭在萌芽状态。

但是依然有很多女性没能做到定期检查,认为检查的时候要暴露自己的隐私部位,很是尴尬,想着能免就免吧。
那么有哪些妇科检查虽然暴露隐私部位,但是还必须要做呢?
妇科检查虽然“羞羞”,但是千万不要省!
去医院进行妇科检查时,要经历和医生沟通和医生检查两大部分。
1.与医生沟通也就是问诊阶段。尤其是很多女性在这一步就开始感觉不好意思,因为可能进入诊室的时候就看到对面一位男性医生,而医生在问诊阶段可能会问到有关个人隐私的一些问题,例如“上次月经是在什么时候”“是否有*生活性**”“是否生育”等等。

其实医生在问这些问题的时候一方面是想缓解进入诊室患者的紧张情绪,另一方面这些问题可以对后面检查可能遇上的妇科疾病做临床参考。所以不要羞涩于回答医生这些问题,一定要诚实回答,避免因为回避问题导致后续检查受到影响。
2.接下来就进入实际检查阶段了,这里需要暴露身体部位的主要是外阴阴道检查和乳房检查。
(1)外阴阴道检查的目的是判断外阴、阴道、宫颈、子宫和子宫附件的健康情况。医生需要进行必要的视诊、触诊。
外阴检查的时候肯定需要脱掉裤子,暴露隐私部位,此时的检查目的是观察外阴的发育情况,是否存在畸形、水肿、溃疡或者肿块,可能医生还会进行触诊查看隐私部位皮肤是否有皮肤变薄、增厚或者萎缩。

另外医生检查时还会重点关注尿道旁腺和前庭大腺是否有肿胀或脓性分泌物,如果有的话就要及时进行涂片检查和细菌培养,以确认炎症与否。
需要观察阴道和宫颈情况的时候,要使用窥阴器检查。通常使用一次性窥阴器,防止交叉感染的发生。医生会使用窥阴器缓慢斜插入阴道内,帮助暴露宫颈、阴道壁和穹隆壁,观察阴道壁颜色、弹性、有无溃疡、肿块、异物。同时观察阴道分泌物的量、性质、颜色及有无异味等。
宫颈的检查重点在子宫颈是否有糜烂、息肉、肿块,或者有无子宫脱垂等情况存在。
除了运用窥阴器检查宫颈和阴道外,医生还会通过触诊进行阴道检查。

医生会在消毒后将食指、中指进入阴道,通过阴道口时可触诊阴道口两侧是否有肿块或触痛,判断是否存在前庭大腺炎或囊肿。接着触及子宫颈关注其硬度、有无接触性出血、疼痛。如果怀疑宫颈管内存在肿瘤时,医生还会伸一指触诊松弛的宫颈管内。
但是进行外阴阴道检查时,要注意避开月经期,最好在月经干净后3-7天进行,因为此时新的子宫内膜刚开始生长,厚度适中,检查时候不至于损伤子宫内膜而引起出血。
如果是未婚者建议禁止做窥阴器检查,但是检查时必须要做的话,医生会先征求意见后才可以进行。另外,还要注意进行检查前务必排空膀胱、必要时排空大便。
(2)乳房检查的目的是通过医生触诊或借助专门仪器检查及时发现乳腺病变。
进行乳房检查时,需要脱掉上衣露出上半身,医生会建议采取坐位、站位或者卧位进行乳房视诊和触诊。
首先医生会观察两侧乳房位置、大小和形态是否正常对称,乳房表面是否有隆起或凹陷。
因为炎症存在的话,患侧的乳房会增大和下垂。同时还要观察乳房皮肤是否发红、水肿、糜烂、酒窝征和橘皮征等,判断是否癌变。
医生进行触诊的时候,会将手掌平贴乳房,按顺时针方向依次触诊,了解乳房有无压痛、结节和肿块。
需要提醒的是,进行乳房检查的时间也应该在月经干净后1周后,尽量选择易穿脱的衣服。
以上我们说到了定期检查和检查项目,那么妇科检查到底该从什么年龄开始?

妇科检查年龄误区解读,清晰不同年龄侧重项目
很多人认为妇科检查要在18岁后才开始,甚至有的人认为要结了婚再开始,其实这都属于误区。
如果是18岁以前的女孩子没有不适症状可以不需要做妇科检查。但是如果出现痛经、腹部包块等,一定要尽早检查就诊。
其实,也并不是只有已婚女性才需要进行妇科检查,很多未婚女孩出现了月经不调、白带增多、异味等疾病,由于羞于检查,结果导致病情延误。
另外,还有的年轻女性还存在生殖器发育不良、子宫位置异常等特殊情况,不进行妇科检查是不容易被发现的。所以未婚女性也要定期进行妇科检查。

另外,还要注意年龄段不同,妇科检查项目的侧重也有不同。
18-45岁是卵巢癌的高发期,因此这个年龄段的女性进行检查时要注意侧重B超检查,预防卵巢癌的发生。跨入30-36岁后,宫颈癌成为了该阶段女性的高发疾病,因此最好每年进行一次宫颈刮片检查、TCT细胞学检查。
35-50岁的女性要多关注自己的乳腺、甲状腺;50岁以后宫颈癌检查就要作为常规项目了。
但是女性不管处于哪个年龄阶段,一旦发现身体出现不适症状,例如乳房胀痛、不过则阴道出血、尿频尿急、白带增多或异味、外阴瘙痒等,都要引起重视,随时前往医院检查明确原因。
明确了检查的重要性后,还是要聊一聊怎么克服检查时的“羞耻感”,关键是要医患“通力合作”?

摒弃“羞耻感”,身体才能更健康
想要患者摒弃检查时的“羞耻感”和放不开,医生应该在检查前对患者进行生殖健康重要性的科普,运用友善的话语、适当的语速安慰患者,缓解患者对检查的畏惧和紧张情绪。
进行检查过程中也要及时对患者的隐私部位进行遮挡或覆盖,如果是男性医生尽量保证在有第三人在场的情况下开展检查,尊重患者隐私和尊严。
那么作为患者也不要太过于畏惧妇科检查,应该注重搜集有关妇科检查和疾病的科普知识,增强关注自身健康意识,对检查医生应抱有信任感,保持放松的状态进行后续检查。
参考文献:
[1]赵玉沛主编. 中华医学百科全书 普通外科学[M]. 北京:中国协和医科大学出版社, 2017.04.
[2]武永芳,李鸿杰,李霞主编. 临床实用医学诊疗与护理研究[M]. 汕头:汕头大学出版社, 2019.03.
[3]牛林敬,董云霞编著. 养乳房护子宫女人健康一生[M]. 石家庄:河北科学技术出版社, 2015.09.
[4]楚超. 半数女士有妇科问题但不重视[N]. 保健时报,2022-03-10(016).DOI:10.28034/n.cnki.nbjsb.2022.000071.
[5]一凡.女性体检项目要随年龄增加[J].现代养生,2015,No.259(21):69-70.
[6]周韵曦. 良言+善举,让妇检不再尴尬[N]. 中国妇女报,2022-03-24(004).DOI:10.28067/n.cnki.ncfnb.2022.000847.
[7]胡海燕,刘则伯. 恶意发布隐私照 妇科检查受影响[N]. 医师报,2023-02-09(A08).DOI:10.44211/n.cnki.nysbz.2023.000093.